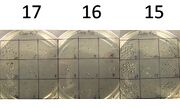

Uploads by Sung-Hye Grieco
From OpenWetWare
Jump to navigationJump to search
This special page shows all uploaded files.
| Date | Name | Thumbnail | Size | Description |
|---|---|---|---|---|
| 21:06, 14 April 2011 | Colony 181920.jpg (file) |  |
33 KB | |
| 21:05, 14 April 2011 | Colony 111314.jpg (file) |  |
60 KB | |
| 21:04, 14 April 2011 | Colonies 789.jpg (file) |  |
50 KB | |
| 23:07, 13 April 2011 | Colony 101112.jpg (file) |  |
57 KB | |
| 22:59, 13 April 2011 | Colony 151617.jpg (file) | |
55 KB | |
| 22:45, 13 April 2011 | Fermentation 181920.jpg (file) |  |
77 KB | |
| 20:24, 12 April 2011 | Fermentation 151617.jpg (file) |  |
84 KB | |
| 19:03, 9 April 2011 | Fermentation 111314.jpg (file) |  |
74 KB | |
| 17:54, 8 April 2011 | Fermentation 101112.jpg (file) |  |
70 KB | |
| 23:56, 7 April 2011 | Colonys 456.jpg (file) |  |
55 KB | |
| 21:08, 7 April 2011 | Fermentation 789.jpg (file) |  |
86 KB | |
| 22:39, 6 April 2011 | Colony 456.jpg (file) |  |
45 KB | |
| 20:22, 6 April 2011 | Fermentation 456.jpg (file) |  |
78 KB | |
| 23:16, 5 April 2011 | Fermentation 123.jpg (file) |  |
74 KB | |
| 22:55, 5 April 2011 | Fermentation profile 123.jpg (file) |  |
1.73 MB | |
| 22:19, 15 February 2011 | BROM-A19 ProductionProfile.JPG (file) |  |
227 KB | |
| 22:19, 15 February 2011 | BROM-A19 FermentationProfile.JPG (file) |  |
342 KB | |
| 23:50, 12 January 2011 | Pichia Screening.jpg (file) |  |
48 KB | |
| 20:06, 13 August 2010 | MeOH-sensor-calibration.JPG (file) |  |
46 KB | |
| 23:32, 10 August 2010 | Fermenter3-20100810.JPG (file) |  |
1.36 MB | |
| 23:11, 10 August 2010 | Fermenter2-20100810.JPG (file) |  |
1.34 MB | |
| 23:03, 10 August 2010 | Fermenter1-20100810.JPG (file) |  |
1.38 MB | |
| 22:45, 10 August 2010 | Autoclave.JPG (file) |  |
1.35 MB | |
| 20:30, 10 August 2010 | Culture-20100810.JPG (file) |  |
1.44 MB | |
| 22:41, 9 August 2010 | DefinedMedia-20100809.JPG (file) |  |
1.16 MB | |
| 22:33, 9 August 2010 | ComplexMedia-20100809.JPG (file) |  |
1.07 MB | |
| 21:39, 9 August 2010 | Culture-20100809-A.JPG (file) |  |
1.35 MB | |
| 17:44, 4 August 2010 | SAP UBC OD600 v DCW.JPG (file) |  |
167 KB | |
| 20:55, 29 July 2010 | Invitrogen Pichia Fermentation Process Guidelines.pdf (file) | 162 KB | ||
| 20:53, 29 July 2010 | Invitrogen Pichia Expression Kit 21 Dec 2009.pdf (file) | 649 KB | ||
| 20:50, 29 July 2010 | SeminarRoomBooking.pdf (file) | 13 KB | ||
| 19:21, 19 July 2010 | SeminarRoomBooking WorkshopSchedule.pdf (file) | 14 KB | ||
| 23:01, 28 June 2010 | 280610.JPG (file) |  |
1.36 MB | |
| 03:48, 28 June 2010 | 270610.JPG (file) |  |
1.38 MB | |
| 18:48, 27 June 2010 | 260610.JPG (file) |  |
1.35 MB | |
| 23:50, 25 June 2010 | Mold C1 (F2) Calibration.jpg (file) |  |
14 KB | |
| 23:29, 25 June 2010 | 250610.JPG (file) |  |
1.38 MB | |
| 00:29, 25 June 2010 | 240610 pm (01).JPG (file) |  |
29 KB | |
| 22:29, 25 January 2010 | CBR.jpg (file) |  |
5 KB | |
| 18:39, 26 March 2009 | Emm29-3-8.pdf (file) | 269 KB | ||
| 19:49, 19 March 2009 | Watsonpump2.tif (file) |  |
79 KB | |
| 00:13, 27 February 2009 | MACG F.xls (file) | 3.51 MB | ||
| 23:20, 26 February 2009 | Jiang J (1993) Biotechnol. Tech.pdf (file) | 299 KB | ||
| 20:52, 28 January 2009 | PB-40-717.pdf (file) | 141 KB | ||
| 20:52, 28 January 2009 | IE13-1-0153.pdf (file) | 423 KB | ||
| 22:42, 23 January 2009 | ReferencePaper5.pdf (file) | 1.25 MB | ||
| 00:31, 21 January 2009 | Watsonpump.tif (file) |  |
543 KB | |
| 21:44, 18 January 2009 | Condenser.jpg (file) |  |
82 KB | |
| 19:00, 18 December 2008 | Test.xls (file) | 14 KB | ||
| 22:24, 25 November 2008 | How to compare last vs current version.wmv (file) | 1.76 MB |